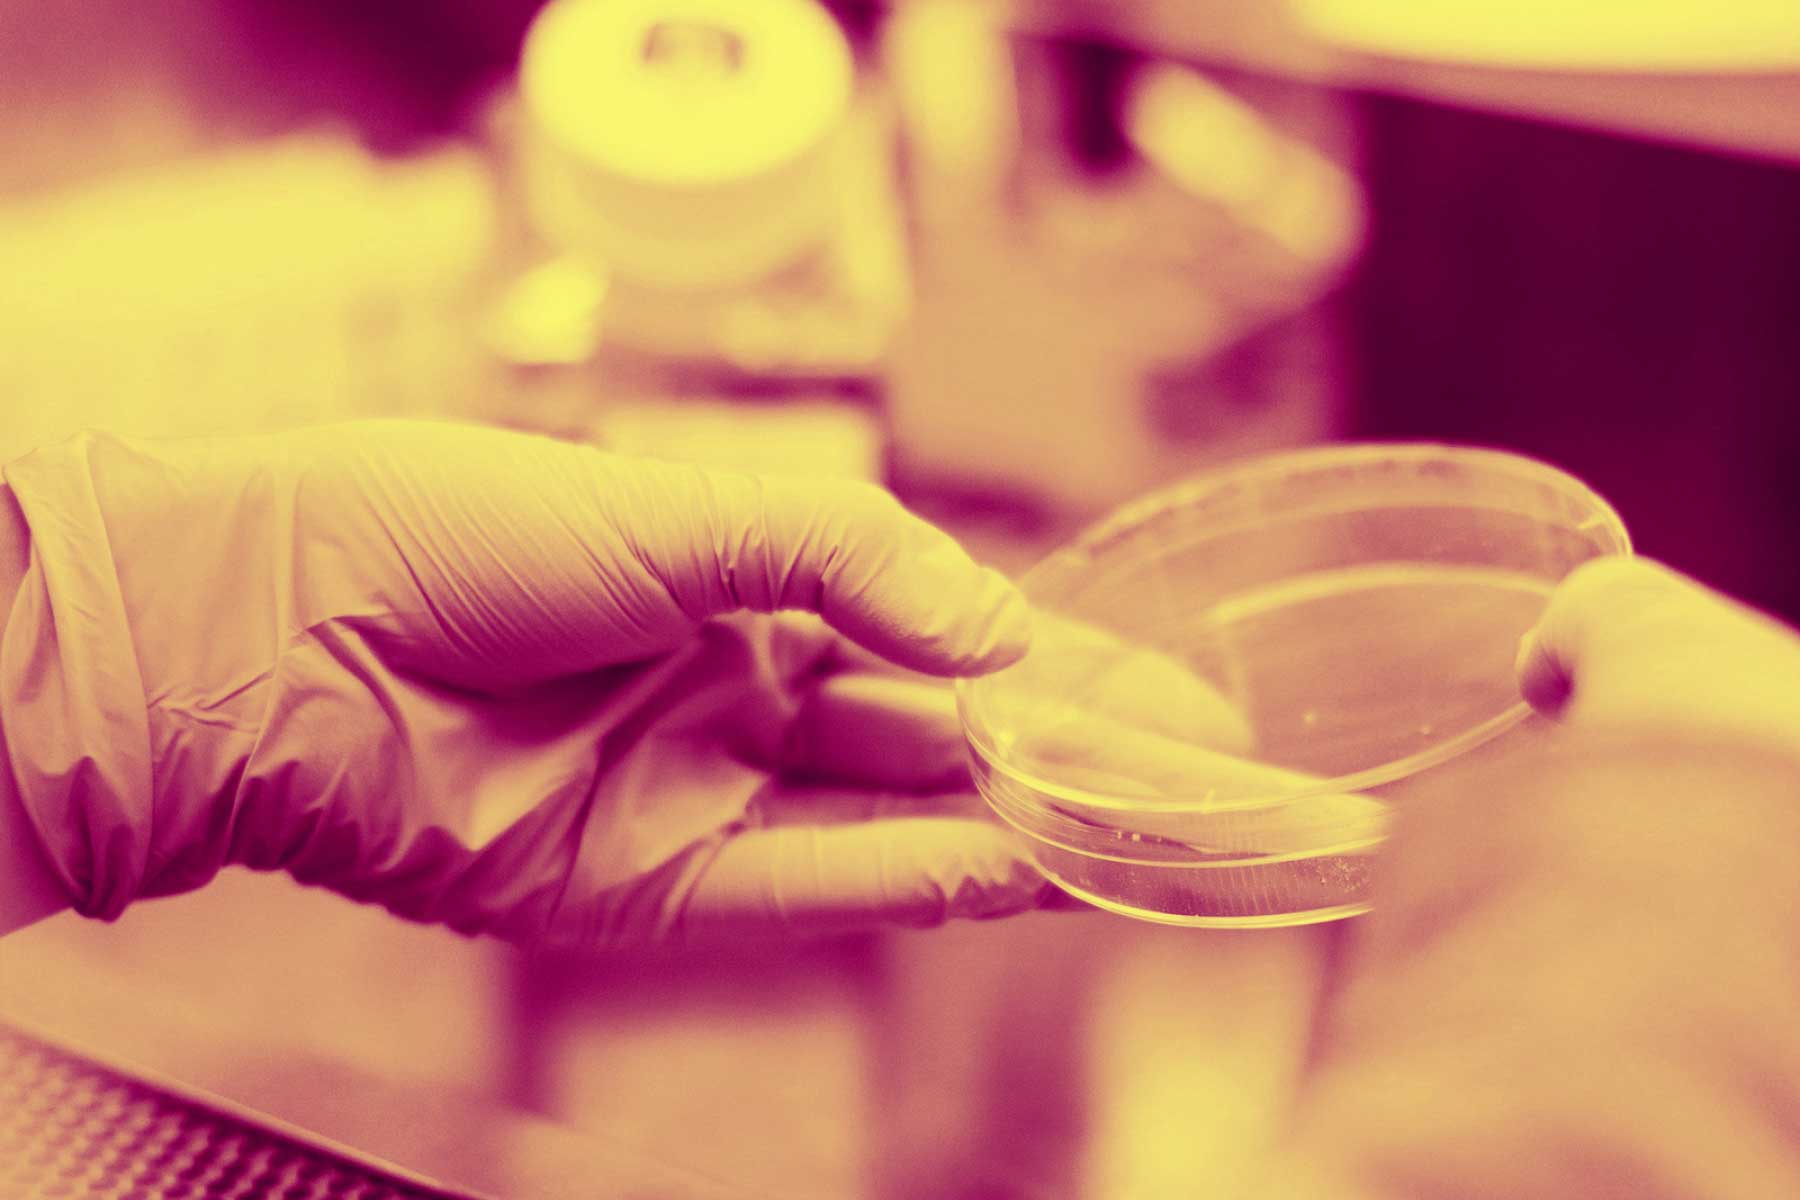

Crear una empresa en Alemania, más fácil.
Alemania es un país lleno de oportunidades, un lugar ideal para convertir su idea empresarial en realidad. Con programas de financiación como la subvención para la creación de empresas existente, le apoyamos en el camino hacia su propia puesta en marcha.
El Centro Global de Certificación y Consultoría (GCCC) está aquí para ayudarle. Le ayudaremos con consultas, revisaremos sus documentos y despejaremos el camino para su visado.
Aproveche las excelentes instalaciones de investigación de Alemania, una sólida red de contactos y la oportunidad de formar parte de una innovadora comunidad de empresas emergentes.
Aproveche las excelentes instalaciones de investigación de Alemania, una sólida red de contactos y la oportunidad de formar parte de una innovadora comunidad de empresas emergentes.